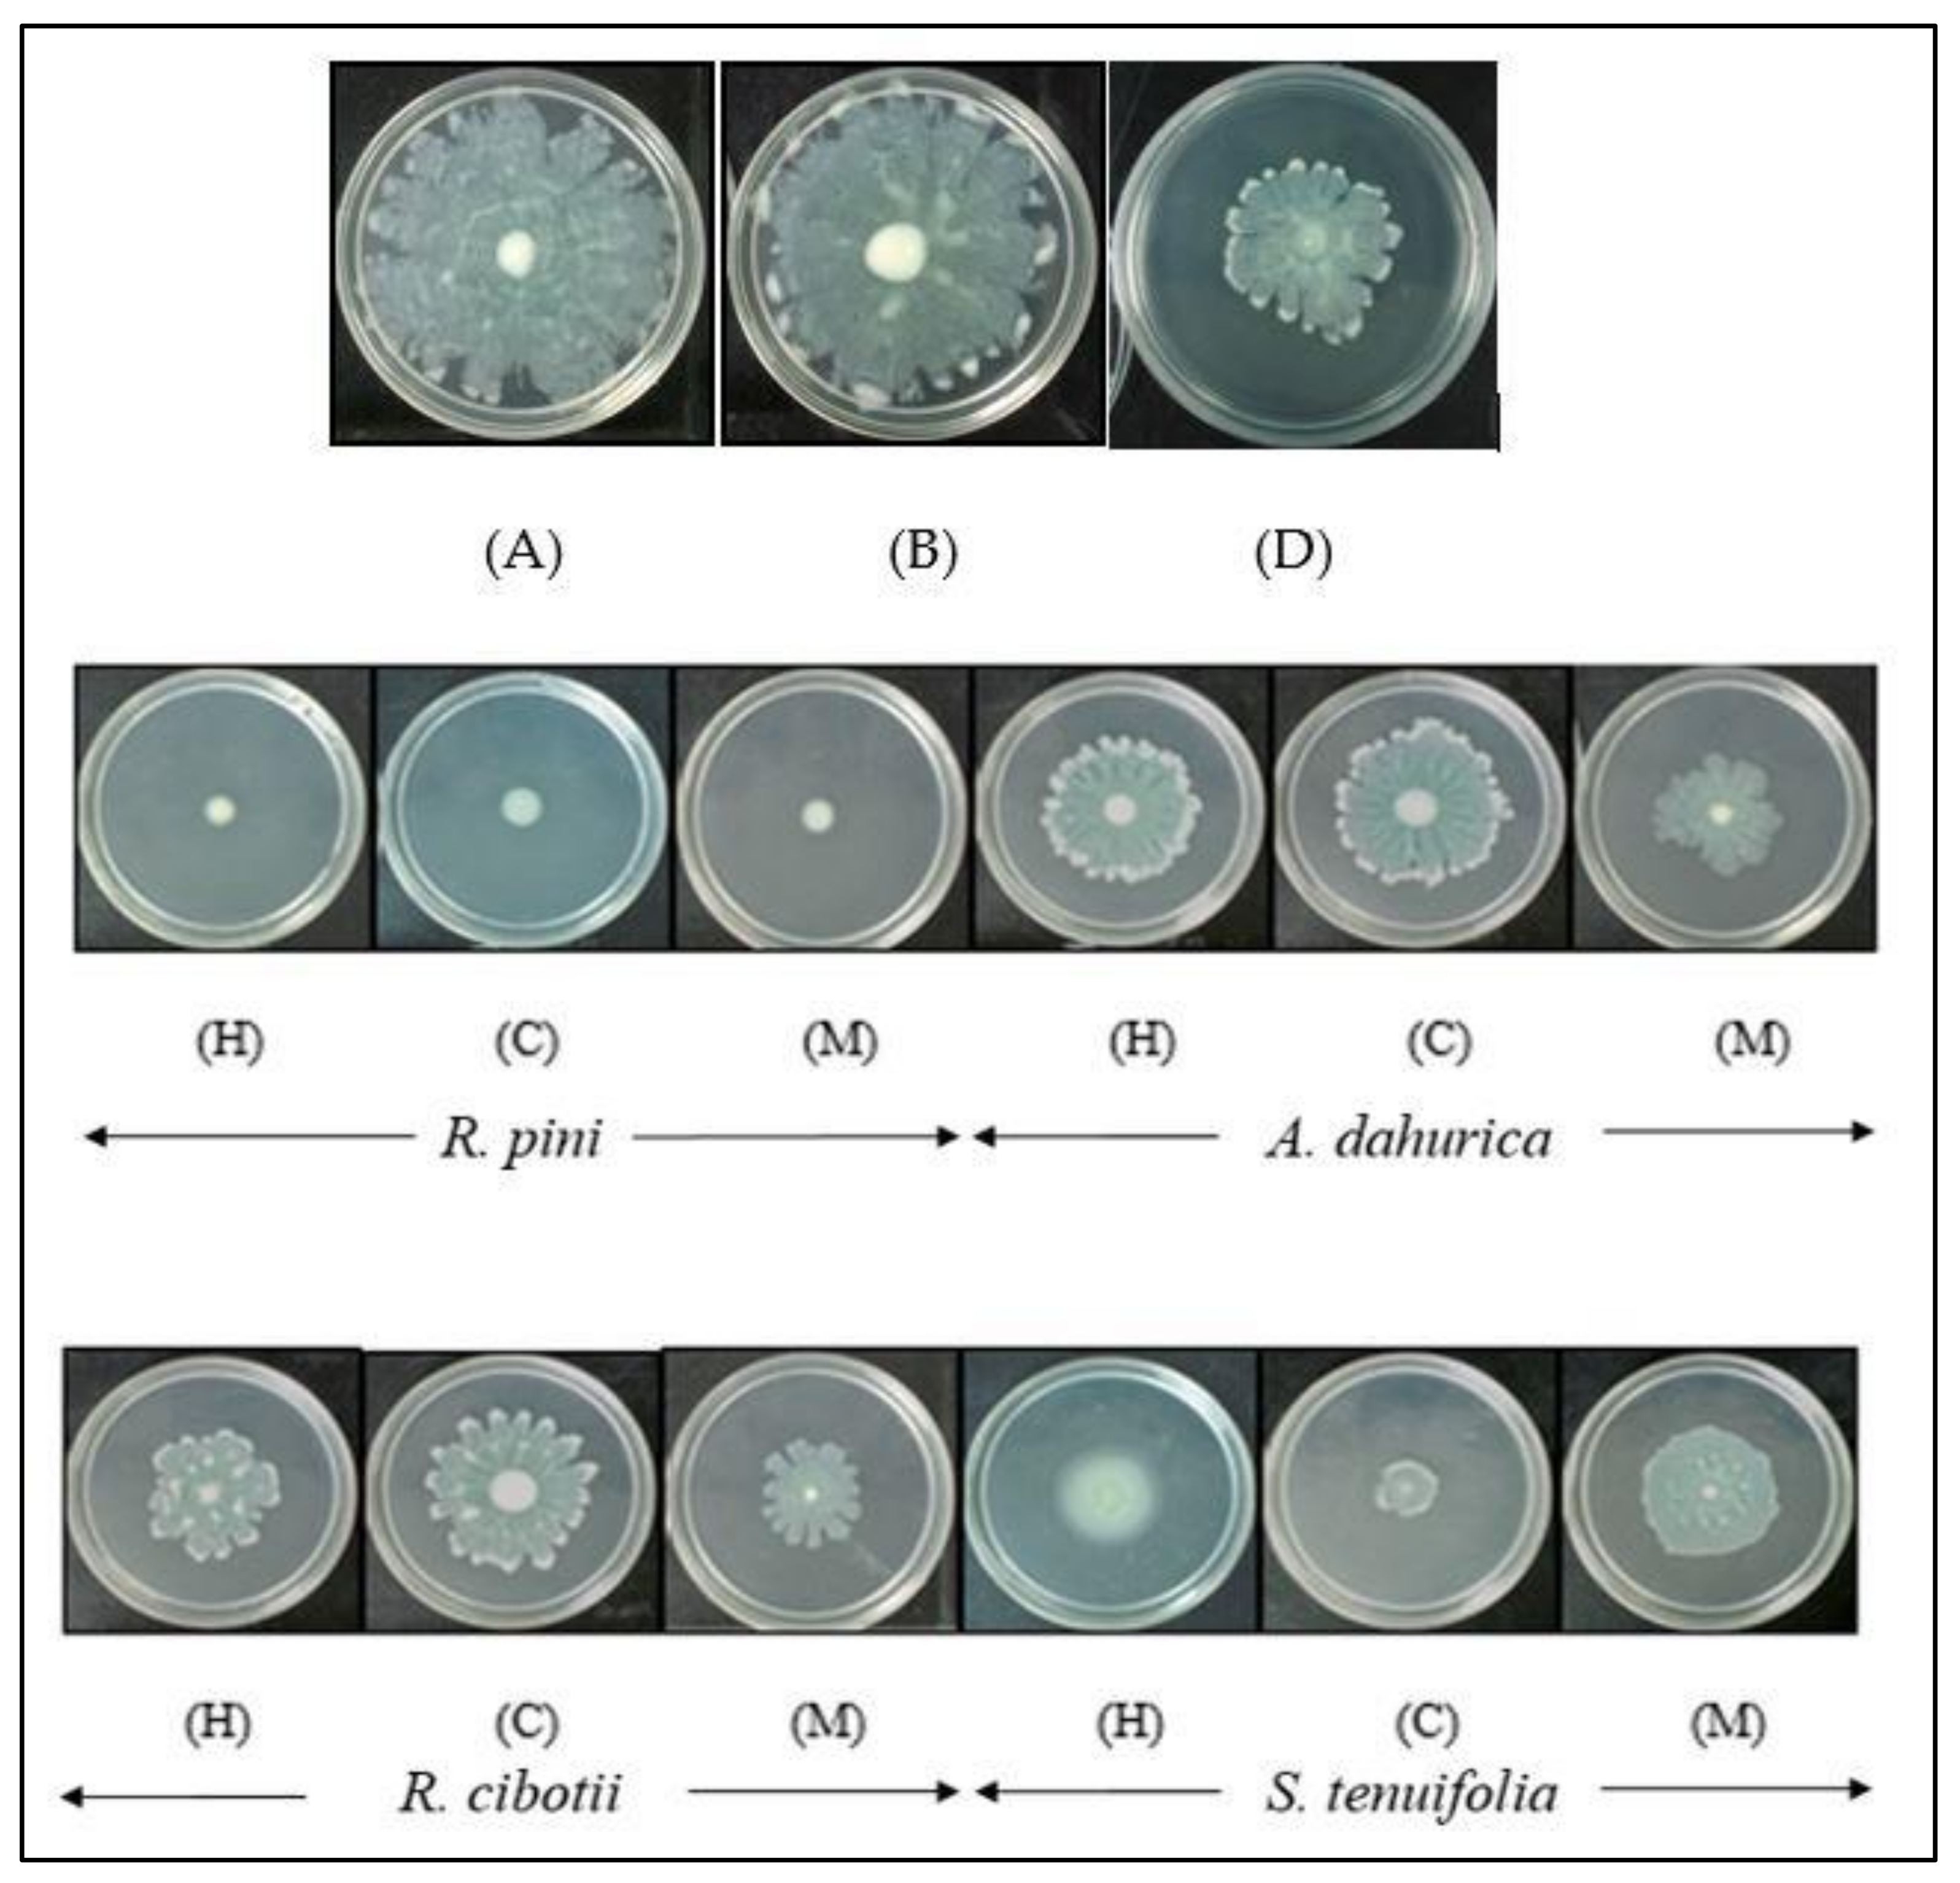

The Effects of Chinese Herbal Medicines on the Quorum Sensing-Regulated Virulence in Pseudomonas aeruginosa PAO1
Abstract
1. Introduction
2. Results and Discussion
2.1. Bacterial Growth
2.2. Screening for Anti-Quorum Sensing Activities
2.2.1. Quantitative Analysis of Violacein Production in C. violaceum CV026
2.2.2. Bioluminescence Assay
2.2.3. Pyocyanin Assay
2.2.4. Swarming Motility Assay
2.3. The Quorum Sensing Inhibition of Other Plant Compounds
3. Materials and Methods
3.1. Bacteria Strains and Culture Conditions
3.2. Plant Samples and Extraction of Crude Extracts
3.3. Bacterial Growth
3.4. Screening for Anti-Quorum Sensing Activities
3.4.1. Quantitative Analysis of Violacein Production by C. violaceum CV026
3.4.2. Bioluminescence Assay
3.4.3. Pyocyanin Assay
3.4.4. Swarming Motility Assay
3.5. Statistical Analysis
4. Conclusions
Supplementary Materials
Acknowledgments
Author Contributions
Conflicts of Interest
References
- Sleigh, J.D.; Timbury, M.C. Notes on Medical Bacteriology, 5th ed.; Churchill Livingstone: London, UK, 1998; ISBN 978-0443058479. [Google Scholar]
- Dong, Y.H.; Gusti, A.R.; Zhang, Q.; Xu, J.L.; Zhang, L.H. Identification of quorum-quenching N-acyl homoserine lactonases from Bacillus species. Appl. Environ. Microbiol. 2002, 68, 1754–1759. [Google Scholar] [CrossRef] [PubMed]
- Henke, J.M.; Bassler, B.L. Three parallel quorum-sensing systems regulate gene expression in Vibrio harveyi. J. Bacteriol. 2004, 186, 6902–6914. [Google Scholar] [CrossRef] [PubMed]
- Pearson, J.P.; Passador, L.; Iglewski, B.H.; Greenberg, E.P. A second N-acylhomoserine lactone signal produced by Pseudomonas aeruginosa. Proc. Natl. Acad. Sci. USA 1995, 92, 1490–1494. [Google Scholar] [CrossRef] [PubMed]
- Lepine, F.; Milot, S. Electrospray/Mass spectrometric identification and analysis of 4-hydroxy-2-alkylquinolones (HAQs) produced by Pseudomonas aeruginosa. J. Am. Soc. Mass Spectrom. 2004, 15, 862–869. [Google Scholar] [CrossRef] [PubMed]
- Lee, J.; Wu, J.; Deng, Y.; Wang, J.; Wang, C.; Wang, J.; Chang, C.; Dong, Y.; Williams, P.; Zhang, L.H. A cell-cell communication signal integrates quorum sensing and stress response. Nat. Chem. Biol. 2013, 9, 339–343. [Google Scholar] [CrossRef] [PubMed]
- Lee, J.; Zhang, L.H. The hierarchy quorum sensing network in Pseudomonas aeruginosa. Protein Cell 2015, 6, 26–41. [Google Scholar] [CrossRef] [PubMed]
- Pollack, M. Pseudomonas aeruginosa. In Principles and Practices of Infectious Diseases; Mandell, G.L., Dolan, R., Bennett, J.E., Eds.; Churchill Livingstone: New York, NY, USA, 1995; ISBN 978-0-8412-3999-9. [Google Scholar]
- Rubin, J.; Walker, R.D.; Blickenstaff, K.; Bodeis-Jones, S.; Zhao, S. Antimicrobial resistance and genetic characterization of fluoroquinolone resistance of Pseudomonas aeruginosa isolated from canine infections. Vet. Microbiol. 2008, 131, 164–172. [Google Scholar] [CrossRef] [PubMed]
- Rasmussen, T.B.; Givskov, M. Quorum sensing inhibitors: A bargain of effects. Microbiology 2006, 152, 895–904. [Google Scholar] [CrossRef] [PubMed]
- Givskov, M.; Nys, R.D.; Manefield, M.; Gram, L.; Maximilien, R.; Eberl, L.; Molin, S.; Steinberg, P.D.; Kjelleberg, S. Eukaryotic interference with homoserine lactone-mediated prokaryotic signaling. J. Bacteriol. 1996, 178, 6618–6622. [Google Scholar] [CrossRef] [PubMed]
- Koh, C.L.; Sam, C.K.; Yin, W.F.; Tan, L.Y.; Krishnan, T.; Chong, Y.M.; Chan, K.G. Plant-derived natural products as sources of anti-quorum sensing compounds. Sensors 2013, 13, 6217–6228. [Google Scholar] [CrossRef] [PubMed]
- Defoirdt, T. Quorum-Sensing Systems as Targets for Antivirulence Therapy. Trends Microbiol. 2018, 26, 313–328. [Google Scholar] [CrossRef] [PubMed]
- Chin, W.Y.; Keng, H. An Illustrated Dictionary of Chinese Medical Herbs; CRCS Publications: Petaluma, CA, USA, 1992; ISBN 9780916360535. [Google Scholar]
- Vickers, A.; Zollman, C. ABC of complementary medicine: Herbal medicine. Br. Med. J. 1999, 319, 1050–1053. [Google Scholar] [CrossRef]
- Hentzer, M.; Givskov, M. Pharmacological inhibition of quorum sensing for the treatment of chronic bacterial infections. J. Clin. Investig. 2003, 112, 1300–1307. [Google Scholar] [CrossRef] [PubMed]
- Truchado, P.; Larrosa, M.; Castro-Ibanez, I.; Allende, A. Plant food extracts and phytochemicals: Their role as Quorum Sensing Inhibitors. Trends Food Sci. Technol. 2015, 43, 189–204. [Google Scholar] [CrossRef]
- Chong, Y.M.; Yin, W.F.; Ho, C.Y.; Mustafa, M.R.; Hadi, A.H.; Awang, K.; Narrima, P.; Koh, C.L.; Appleton, D.R.; Chan, K.G. Malabaricone C from Myristica cinnamomea exhibits anti-quorum sensing activity. J. Nat. Prod. 2011, 74, 2261–2264. [Google Scholar] [CrossRef] [PubMed]
- Tan, L.Y.; Yin, W.F.; Chan, K.G. Silencing quorum sensing through extracts of Melicop lunu-ankenda. Sensors 2012, 12, 4339–4351. [Google Scholar] [CrossRef] [PubMed]
- Priya, K.; Yin, W.F.; Chan, K.G. Anti-quorum sensing activity of the Chinese traditional herb. Phyllantus amarus. Sensors 2013, 13, 14558–14569. [Google Scholar] [CrossRef] [PubMed]
- Rasmussen, T.B.; Bjarnsholt, T.; Skindersoe, M.E.; Hentzer, M.; Kristoffersen, P.; Kote, M.; Nielsen, J.; Eberl, L.; Givskov, M. Screening for quorum-sensing inhibitors (QSI) by use of a novel genetic system, the QSI Selector. J. Bacteriol. 2005, 187, 1799–1814. [Google Scholar] [CrossRef] [PubMed]
- Teplitski, M.; Robinson, J.B.; Bauer, W.D. Plants secrete substances that mimic bacterial N-acyl homoserine lactone signal activities and affect population density-dependent behaviors in associated bacteria. Mol. Plant-Microbe Interact. 2000, 13, 637–648. [Google Scholar] [CrossRef] [PubMed]
- Adonizio, A.L.; Downum, K.; Bennet, B.C.; Mathee, K. Anti-quorum sensing activity of medicinal plants in southern Florida. J. Enthnopharmacol. 2006, 105, 427–435. [Google Scholar] [CrossRef] [PubMed]
- Gram, L.; de Nys, R.; Maximilien, R.; Givskov, M.; Steinberg, P.; Kjelleberg, S. Inhibitory effects of secondary metabolites from the red alga Delisea pulchra on swarming motility of Proteus Mirabilis. Appl. Environ. Microbiol. 1996, 62, 4284–4287. [Google Scholar] [PubMed]
- Hentzer, M.; Wu, H.; Andersen, J.B.; Riedel, K.; Rasmussen, T.B.; Bagge, N.; Kumar, N.; Schembri, M.A; Song, Z.; Kristoffersen, P.; et al. Attenuation of Pseudomonas aeruginosa virulence by quorum sensing inhibitors. EMBO J. 2003, 22, 3803–3815. [Google Scholar] [CrossRef] [PubMed]
- McClean, K.H.; Winson, M.K.; Fish, L.; Taylor, A.; Chhabra, S.R.; Cámara, M.; Daykin, M.; Lamb, J.H.; Swift, S.; Bycroft, B.W.; et al. Quorum sensing and Chromobacterium violaceum: Exploitation of violacein production and inhibition for the detection of N-acylhomoserine lactones. Microbiology 1997, 143, 3703–3711. [Google Scholar] [CrossRef] [PubMed]
- Konzen, M.; Marco, D.D.; Cordova, C.A.S.; Vieira, T.O.; Antonio, R.G.; Creczynski-Pasa, T.B. Antioxidant properties of violacein: Possible relation on its biological function. Bioorg. Med. Chem. 2006, 14, 8307–8313. [Google Scholar] [CrossRef] [PubMed]
- Winson, M.K.; Swift, S.; Fish, L.; Throup, J.P.; Jorgensen, F.; Chhabra, S.R.; Bycroft, B.W.; Williams, P.; Stewart, G.S.A.B. Construction and analysis of luxCDABE-based plasmid sensors for investigating N-acyl homoserine lactone-mediated quorum sensing. FEMS Microbiol. Lett. 1998, 163, 185–192. [Google Scholar] [CrossRef] [PubMed]
- Cámara, M.; Williams, P.; Hardman, A. Controlling infection by tuning in and turning down the volume of bacterial small-talk. Lancet Infect. Dis. 2002, 2, 667–676. [Google Scholar] [CrossRef]
- Brint, J.M.; Ohman, D.E. Synthesis of multiple exoproducts in Pseudomonas aeruginosa is under the control of RhlR-RhlI, another set of regulators in strain PAO1 with homology to the autoinducer-responsive LuxR-LuxI family. J. Bacteriol. 1995, 177, 7155–7163. [Google Scholar] [CrossRef] [PubMed]
- Gallagher, L.A.; Mcknight, S.L.; Kuznetsova, M.S.; Pesci, E.C.; Manoil, C. Functions required for extracellular quinolone signaling by Pseudomonas aeruginosa. J. Bacteriol. 2002, 184, 6472–6480. [Google Scholar] [CrossRef] [PubMed]
- Lau, G.W.; Hassett, D.J.; Ran, H.; Kong, F. The role of pyocyanin in Pseudomonas aeruginosa infection. Trends Mol. Med. 2004, 10, 599–606. [Google Scholar] [CrossRef] [PubMed]
- Venturi, V. Regulation of quorum sensing in Pseudomonas. FEMS Microbiol. Rev. 2006, 30, 274–291. [Google Scholar] [CrossRef] [PubMed]
- Köhler, T.; Curty, L.K.; Barja, F.; van Delden, C.; Pechère, J.C. Swarming of Pseudomonas aeruginosa is dependent on cell-to-cell signaling and requires flagella and pili. J. Bacteriol. 2000, 182, 5990–5996. [Google Scholar] [CrossRef] [PubMed]
- Harshey, R.M. Bees aren’t the only ones: Swarming in Gram-negative bacteria. Mol. Microbiol. 1994, 13, 389–394. [Google Scholar] [CrossRef] [PubMed]
- Rashid, M.H.; Kornberg, A. Inorganic polyphosphate is needed for swimming, swarming, and twitching motilities in Pseudomonas aeruginosa. Proc. Natl. Acad. Sci. USA 2000, 97, 4885–4890. [Google Scholar] [CrossRef] [PubMed]
- Manefield, M.; Rasmussen, T.B.; Henzter, M.; Andersen, J.B.; Steinberg, P.; Kjelleberg, S.; Givskov, M. Halogenated furanones inhibit quorum sensing through accelerated LuxR turnover. Microbiology 2002, 148, 1119–1127. [Google Scholar] [CrossRef] [PubMed]
- Rodrigues, A.C.; Zola, F.G.; Avila, O.B.; Sacramento, N.T.; da Silva, E.R.; Bertoldi, M.C.; Taylor, J.G.; Pinto, U.M. Quorum Quenching and Microbial Control through Phenolic Extract of Eugenia Uniflora Fruits. J. Food Sci. 2016, 81, M2538–M2544. [Google Scholar] [CrossRef] [PubMed]
- Rodrigues, A.C.; de Oliveira, B.D.; da Silva, E.R.; Sacramento, N.T.; Bertoldi, M.C.; Pinto, U.M. Anti-quorum sensing activity of phenolic extract from Eugenia brasiliensis (Brazilian cherry). Food Sci. Technol. 2016, 36, 337–434. [Google Scholar] [CrossRef]
- Oliveira, B.D.A.; Rodrigues, A.C.; Cardoso, B.M.I.; Ramos, A.L.C.C.; Bertoldi, M.C.; Taylor, J.G.; da Cunha, L.R.; Pinto, U.M. Antioxidant, antimicrobial and anti-quorum sensing activities of Rubus rosaefolius phenolic extract. Ind. Crops Prod. 2016, 84, 59–66. [Google Scholar] [CrossRef]
- Vasavi, H.S.; Arun, A.B.; Rekha, P.D. Anti-quorum sensing activity of flavonoid-rich fraction from Centella asiatica L. against Pseudomonas aeruginosa PAO1. J. Microbiol. Immunol. Infect. 2016, 49, 8–15. [Google Scholar] [CrossRef] [PubMed]
- Vandeputte, O.M.; Kiendrebeogo, M.; Rajaonson, S.; Diallo, B.; Mol, A.; Jaziri, M.E.; Baucher, M. Identification of catechin as one of the flavonoids from Combretum albiflorum bark extract that reduces the production of quorum-sensing-controlled virulence factors in Pseudomonas aeruginosa PAO1. Appl. Environ. Microbiol. 2010, 76, 243–253. [Google Scholar] [CrossRef] [PubMed]
- Rasamiravaka, T.; Jedrzejowski, A.; Kiendrebeogo, M.; Rajaonson, S.; Randriamampionona, D.; Rabemanantsoa, C.; ANdriantsimahavandy, A.; Rasamindrakotroka, A.; Duez, P.; El Jaziri, M.; et al. Endemic malagasy Dalbergia species inhibit quorum sensing in Pseudomonas aeruginosa PAO1. Microbiology 2013, 159, 924–938. [Google Scholar] [CrossRef] [PubMed]
- Bouyahya, A.; Dakka, N.; Et-Touys, A.; Abrini, J.; Bakri, Y. Medicinal plant products targeting quorum sensing for combating bacterial infections. Asian Pac. J. Trop. Med. 2017, 10, 729–743. [Google Scholar] [CrossRef] [PubMed]
- Paczkowski, J.E.; Mukherjee, S.; McCready, A.R.; Cong, J.P.; Aquino, C.J.; Kim, H.; Henke, B.R.; Smith, C.D.; Bassler, B.L. Flavonoids Suppress Pseudomonas aeruginosa Virulence through Allosteric Inhibition of Quorum-sensing Receptors. J. Biol. Chem. 2017, 292, 4064–4076. [Google Scholar] [CrossRef] [PubMed]
- Ismail, T.; Sestili, P.; Akhtar, S. Pomegranate peel and fruit extracts: A review of potential anti-inflammatory and anti-infective effects. J. Ethnopharmacol. 2012, 143, 397–405. [Google Scholar] [CrossRef] [PubMed]
- Truchado, P.; Tomás-Barberán, F.A.; Larrosa, M.; Allende, A. Food phytochemicals act as quorum sensing inhibitors reducing production and/or degrading autoinducers of Yersinia enterocolitica and Erwinia carotovora. Food Control 2012, 24, 78–85. [Google Scholar] [CrossRef]
- Starkey, M.; Lepine, F.; Maura, D.; Bandyopadhaya, A.; Lesic, B.; He, J.; Kitao, T.; Righi, V.; Milot, S.; Tzika, A.; et al. Identification of anti-virulence compounds that disrupt quorum-sensing regulated acute and persistent pathogenicity. PLoS Pathog. 2014, 10, e1004321. [Google Scholar] [CrossRef] [PubMed]
- Koch, B.; Liljefors, T.; Persson, T.; Nielsen, J.; Kjelleberg, S.; Givskov, M. The LuxR receptor: The sites of interaction with quorum-sensing signals and inhibitors. Microbiology 2005, 151, 3589–3602. [Google Scholar] [CrossRef] [PubMed]
- Garcia-Contreras, R.; Maeda, T.; Wood, T.K. Resistance to quorum-quenching compounds. Appl. Environ. Microbiol. 2013, 79, 6840–6846. [Google Scholar] [CrossRef] [PubMed]
- Maura, D.; Ballok, A.E.; Rahme, L.G. Considerations and caveats in anti-virulence drug development. Curr. Opin. Microbiol. 2016, 33, 41–46. [Google Scholar] [CrossRef] [PubMed]
- Chan, K.G.; Atkinson, S.; Mathee, K.; Sam, C.K.; Chhabra, S.R.; Cámara, M.; Koh, C.L.; Williams, P. Characterization of N-acylhomoserine lactone-degrading bacteria associated with the Zingiber officinale (ginger) rhizosphere: Co-existence of quorum quenching and quorum sensing in Acinetobacter and Burkholderia. BMC Microbiol. 2011, 11, 51. [Google Scholar] [CrossRef] [PubMed]
- Feng, X.J.; Fu, J.Y.; Liu, F. Clinical Observation on the Combined Use of Acupuncture and Herbal Medicine for Treatment of Chloasma. J. Tradit. Chin. Med. 2010, 30, 15–17. [Google Scholar] [CrossRef]
- Tong, X.G.; Liu, J.L.; Cheng, Y.X. A new pregnane steroid from Poria cum radix pini. J. Asian Nat. Prod. Res. 2010, 95, 47–55. [Google Scholar]
- Kimura, T.; But, P.P.H.; Guo, J.X.; Sung, C.K. International Collection of Traditional and Folk Medicine: Part 1; World Scientific: Singapore, 1996; pp. 117–118. ISBN 978-981-02-2589-6. [Google Scholar]
- Yang, S.Z. The Divine Farmer’s Materia Medica; Blue Poppy Press: Boulder, CO, USA, 1998; p. 58. ISBN 978-0936185965. [Google Scholar]
- Pei, G.X.; Da, P.L.; Shi, L.Y. New Edited Record of TCM (Volume 1); China Chemical Industry Press: Beijing, China, 2002; pp. 337–343. [Google Scholar]
- Xu, Z.Y.; Chen, Z.D.; Chen, Z.L.; Hou, L.B. The progress in research of Cibotium barometz. J. Chin. Med. Mater. 2000, 23, 160–161. [Google Scholar]
- Zhao, Y.; Zhu, J.Y.; Zhang, G.J. Chinese Medicine (Basis and Application of TCM); People’s Medical Publishing House: Beijing, China, 2007. [Google Scholar]
- China Pharmacopoeia Committee. Chinese Pharmacopoeia (Volume 1); Chemical Industry Press: Beijing, China, 2010; ISBN 9787506744393. [Google Scholar]
- Chang, H.M.; But, P.P.H. Pharmacology and Applications of Chinese Materia Medica (Volume 2); World Scientific: Singapore, 1986; ISBN 978-9971-5-0167-9. [Google Scholar]
- Kim, C.J.; Lim, J.S.; Cho, S.K. Anti-diabetic agents from medicinal plants inhibitory activity of Schizonepeta tenuifolia spikes on the diabetogenesis by Streptozotocin in mice. Arch. Pharm. Res. 1996, 19, 441–446. [Google Scholar] [CrossRef]
- Zhu, Y.P. Chinese Materia Medica: Chemistry, Pharmacology and Applications; CRC Press: Boca Raton, FL, USA, 1998; ISBN 90-5702-285-0. [Google Scholar]
- Hayouni, E.A.; Bouix, M.; Abedrabba, M.; Leveau, J.Y.; Hamdi, M. Mechanism of action of Melaleuca armillaris [Sol. Ex Gaertu] Sm. essential oil on six LAB strains as assessed by multiparametric flow cytometry and automated microtiter-based assay. Food Chem. 2008, 111, 707–718. [Google Scholar] [CrossRef]
- Diggle, S.P.; Winzer, K.; Lazdunski, A.; Williams, P.; Cámara, M. Advancing the Quorum Sensing in Pseudomonas aeruginosa: MvaT and the Regulation of N-Acylhomoserine Lactone Production and Virulence Gene Expression. J. Bacteriol. 2002, 184, 2576–2586. [Google Scholar] [CrossRef] [PubMed]
- Chen, B.G.; Turner, L.; Berg, H.C. The Wetting Agent Required for Swarming in Salmonella enteric Serovar Typhimurium is Not a Surfactant. J. Bacteriol. 2007, 189, 8750–8753. [Google Scholar] [CrossRef] [PubMed]
- Pesci, E.C.; Pearson, J.P.; Seed, P.C.; Iglewski, B.H. Regulation of las and rhl quorum sensing in Pseudomonas aeruginosa. J. Bacteriol. 1997, 179, 3127–3132. [Google Scholar] [CrossRef] [PubMed]
Sample Availability: Not Available. |

| Strains or Plasmids | Relevant Genotype/Description | Reference/Source |
|---|---|---|
| P. aeruginosa PAO1 | Wild type prototroph 21 | [52] |
| C. violaceum CV026 | Double mini-Tn5 mutant derived from ATCC 31532 * KanR, * HgR, cviI::Tn5 xylE, plus spontaneous * StrR, AHL biosensor | [26] |
| E. coli (pSB401) | luxR/I (Photobacterium fischeri [ATCC 7744])::luxCDABE (Photorhabdus luminescens [ATCC 299999]) pACYC184-derived, * TetR | [28] |
| E. coli (pSB1075) | lasR/I (P. aeruginosa PAO1)::luxCDABE (Photorhabdus luminescens [ATCC 299999]) fusion in * TetR | [28] |
| Plants | Ommon Name | Part of Plant Tested | Pharmacological/Medicinal Uses |
|---|---|---|---|
| Poria cum Radix pini [RP] | Poria spirit/‘Fu shen’ | Sclerotia | Eliminate dampness, insomnia, promotes urination, strengthens spleen and stomach, sedative activity [53,54] |
| Angelica dahurica [AD] | Root of the holy ghost/Wild angelica/‘Bai zhi’ | Roots | Antidote for acne, ulcer, rheumatism, headache, rhinitis, abdominal pain, hysteria, skin diseases, erythema, toothache, sinusitis [55,56,57] |
| Rhizoma cibotii [RC] | Chain fern rhizome/‘Gouji’ | Rhizomes | Replenish liver and kidney, strengthen bones and muscles, treatment of chronic rheumatism, backache, leucorrhea spermatorrhea, hemiplegia, numbness [58,59,60] |
| Schizonepeta tenuifolia [ST] | ‘Jing Jie’ | Whole plant | Fever, anti-inflammatory, diaphoretic, analgesic, anti-febrile, anti-spasmodic, headache, allergic dermatitis, eczema, psoriasis [61,62,63] |
© 2018 by the authors. Licensee MDPI, Basel, Switzerland. This article is an open access article distributed under the terms and conditions of the Creative Commons Attribution (CC BY) license (http://creativecommons.org/licenses/by/4.0/).
Share and Cite
Chong, Y.M.; How, K.Y.; Yin, W.F.; Chan, K.G. The Effects of Chinese Herbal Medicines on the Quorum Sensing-Regulated Virulence in Pseudomonas aeruginosa PAO1. Molecules 2018, 23, 972. https://doi.org/10.3390/molecules23040972
Chong YM, How KY, Yin WF, Chan KG. The Effects of Chinese Herbal Medicines on the Quorum Sensing-Regulated Virulence in Pseudomonas aeruginosa PAO1. Molecules. 2018; 23(4):972. https://doi.org/10.3390/molecules23040972
Chicago/Turabian StyleChong, Yee Meng, Kah Yan How, Wai Fong Yin, and Kok Gan Chan. 2018. "The Effects of Chinese Herbal Medicines on the Quorum Sensing-Regulated Virulence in Pseudomonas aeruginosa PAO1" Molecules 23, no. 4: 972. https://doi.org/10.3390/molecules23040972
APA StyleChong, Y. M., How, K. Y., Yin, W. F., & Chan, K. G. (2018). The Effects of Chinese Herbal Medicines on the Quorum Sensing-Regulated Virulence in Pseudomonas aeruginosa PAO1. Molecules, 23(4), 972. https://doi.org/10.3390/molecules23040972

